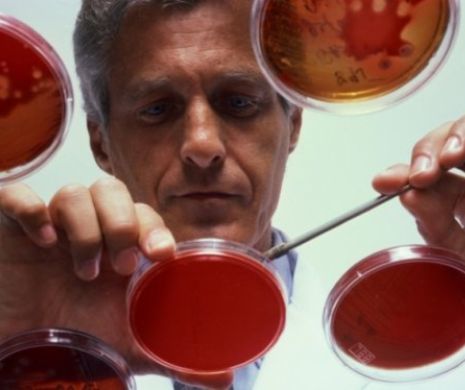
INAMICUL NECUNOSCUT din aer. Rezistența la TRATAMENT face EPIDEMIILE să fie IMPREVIZIBILE și MORTALE

TEXTUL DENUNȚULUI făcut de Orban împotriva premierului Dăncilă. ÎNALTĂ TRĂDARE, uzurparea funcției și DIVULGARE de informații nepublice - FOTO
Noi detalii privind denunțul făcut de liderul PNL, Ludovic Orban, împotriva premierului Viorica Dăncilă au ieșit la iveală, duminică. În documentul de 20 de pagini se vorbește despre mai multe...